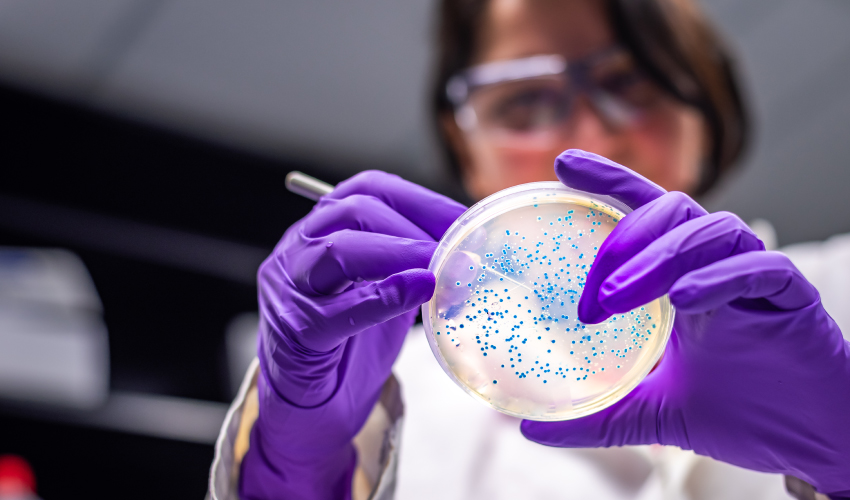

Live class
BR
EN

Notícias
Destaque
Ativos Cosméticos
Caféina e Adenosina: Impactos no Microbioma e Lipidoma do Couro Cabeludo e sua Relação com a Queda Capilar
O futuro do colágeno já começou — e ele é vegano, biotecnológico e baseado em ciência.
Você ainda formula com sulfatos e glicosídeos?
Melanina sintética promove reparos de tecidos
Fortalecendo a Barreira Cutânea
Notícias do Mercado

Indústria de Embalagens de Luxo Une Sustentabilidade à Qualidade e Experiência
Tendências

A nova geração da fotoproteção já começou.